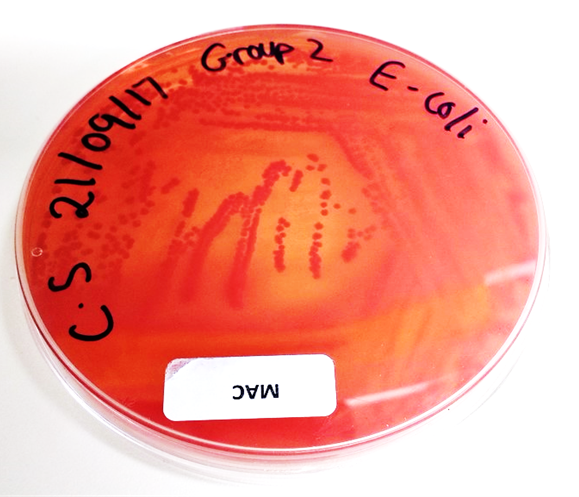
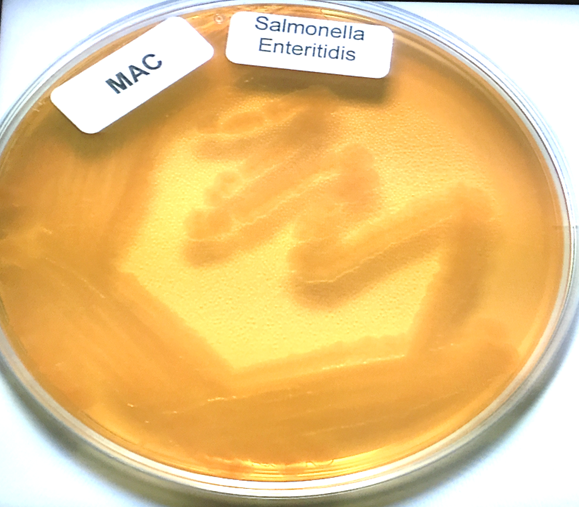

1/538
Looks like no tags are added yet.
Name | Mastery | Learn | Test | Matching | Spaced | Call with Kai |
|---|
No study sessions yet.
What is an example of a bacteria that causes skin infection?
staphylococcus aureus
What is an example of a bacteria that causes upper respiratory tract infection?
streptococcus pyogenes
What is an example of a bacteria that causes urinary tract infection?
Escherichia coli
What are differences between eukaryotes and prokaryotes?
EUKARYOTES | PROKARYOTES |
Large cell | Small cell |
Organelles present | Organelles absent - genetic info loose in cytoplasm (no nucleus) |
Multiple linear chromosomes | 1 circular chromosome (+plasmids) |
No cell wall (except for FUNGI) | Cell wall (BACTERIA) |
80S ribosomes | 70S ribosomes |
What part of bacteria do antibiotics target (in order to kill the cell)?
primarily the cell wall
What does a colony on an agar plate consist of?
one colony consists of many bacteria cells which is why its visible to the naked eye (one cell requires a microscope to be seen)
What does MacConkey agar consist of?
peptones
lactose
bile salts and crystal violet (inhibit gram +ve bacteria)
neutral red (pH indicator)
What colour does MacConkey agar turn into when bacteria ferment lactose?
Why does it turn that colour?
turns red
due to the bacteria (E.coli or klebsiella) turning lactose → lactic acid
this lowers pH
pH indicator causes red medium and red colonies with a surrounding zone of precipitated bile salts (haziness)
What colour does MacConkey agar turn into when bacteria does not ferment lactose?
Why does it turn that colour?
yellow medium agar with colourless colonies
uses peptone instead of lactose which causes ammonia to be formed → higher pH (more alkali)
What are some bacteria that turn MacConkey agar red?
What are some bacteria that turn MacConkey agar yellow?
Escherichia Coli and Klebsiella as they both ferment lactose
Salmonella and Pseudomonas Aeruginosa
What is a round bacteria cell called?
coccus (singular) or cocci (plural) shaped
What is a rectangular/oblong bacteria cell called?
rod shaped
What does strep cells look like (in terms of arrangement)?
look like they are arranged in a line
What do staph cells look like (in terms of arrangement)?
are stacked together
What is the difference between streptococci and staphylococci shaped cells?
strep = line, staph = stacked

What shape would a bacillus cell be?
rod shaped

What colour would gram +ve bacteria be?
purple
What colour would gram -ve bacteria be?
pink
What is the gram staining process steps for bacteria?
crystal violet used first (turns +ve and -ve purple at first)
iodine
decolourisation (if +ve remains purple, if -ve goes back to clear)
safranin is used as a counter stain = binds to gram -ve
turns gram -ve pink
Does gram +ve bacteria have thicker or thinner cell wall?
has a thicker cell wall

What part of bacterial cell dictated whether the cell is gram -ve or +ve?
the cell wall
What is the bacterial cell wall composed of?
What characteristics does this cell wall have?
peptidoglycan layers (sugar and peptide layers)
results in a very rigid structure
Does gram +ve or gram -ve have thinner cell wall?
gram -ve
Why are gram -ve bacteria harder to treat?
because has 2 membranes that drug needs to be able to go through and the lipopolysaccharides on outer membrane acts as a barrier

What do gram -ve bacteria have that gram +ve bac do not?
What is it for?
has an extra layer made up of lipopolysaccharides
is an extra layer of protection

What are porins, where are they located and what do they do?
are channels located in gram -ve bacteria in the outer membrane that let small hydrophilic molecules go past the outer membrane and into the cell

What are 3 gram +ve cocci?
Staphylococcus aureus
Streptococcus pyogenes
Enterococcus faecalis
Cocci | Rods | |
Gram + | Staphylococcus aureus Streptococcus pyogenes Enterococcus faecalis | Clostridioides botulinum Clostridioides difficile Clostridioides perfringens Clostridioides tetani |
Gram - | Neisseria gonorrhoeae Neisseria meningitidis | Escherichia coli Pseudomonas aeruginosa Klebsiella pneumoniae Haemophilus influenza |
What are 2 gram -ve cocci?
Neisseria gonorrhoeae
Neisseria meninigitis
Cocci | Rods | |
Gram + | Staphylococcus aureus Streptococcus pyogenes Enterococcus faecalis | Clostridioides botulinum Clostridioides difficile Clostridioides perfringens Clostridioides tetani |
Gram - | Neisseria gonorrhoeae Neisseria meningitidis | Escherichia coli Pseudomonas aeruginosa Klebsiella pneumoniae Haemophilus influenza |
What are 4 gram+ rods?
Clostridioides botulinum
Clostridioides difficlle
Clostridioides perfringens
Clostridioides tetani
Cocci | Rods | |
Gram + | Staphylococcus aureus Streptococcus pyogenes Enterococcus faecalis | Clostridioides botulinum Clostridioides difficile Clostridioides perfringens Clostridioides tetani |
Gram - | Neisseria gonorrhoeae Neisseria meningitidis | Escherichia coli Pseudomonas aeruginosa Klebsiella pneumoniae Haemophilus influenza |
What are 4 examples of gram -ve rods?
Escherichia coli
Pseudomonas aeruginosa
Klebsiella pneumoniae
Haemophilus influenza
Cocci | Rods | |
Gram + | Staphylococcus aureus Streptococcus pyogenes Enterococcus faecalis | Clostridioides botulinum Clostridioides difficile Clostridioides perfringens Clostridioides tetani |
Gram - | Neisseria gonorrhoeae Neisseria meningitidis | Escherichia coli Pseudomonas aeruginosa Klebsiella pneumoniae Haemophilus influenza |
What problems does Escherichia coli cause?
gastroenteritis, UTI, neonatal meningitis
What bacteria causes 90% of UTIs?
Escherichia coli
What problems does Pseudomonas aeruginosa cause?
pneumonia and infections in cystic fibrosis, burn injuries and nosocomial infections
Where do people tend to contract Pseudomonas Aeruginosa?
in the hospital a lot of the time
What problems does Staphylococcus aureus cause?
skin and soft tissue infections, bone/joint infections, endocarditis, toxic shock syndrome and food poisoning
What problems does Streptococcus pyogenes cause?
skin/throat infections e.g. → erysipelas/cellulitis and pharyngitis
What are mycobacteria?
neither gram +ve or -ve.
myco = like a fungus
What are examples of mycobacteria?
mycobacterium tuberculosis
mycobacterium avium complex → pulmonary infection in immunocompromised people
mycobacterium leprae → leprosy
What stain is used for mycobacteria?
What is the colour change?
Ziehl-Neelson’s (ZN) stain used
goes from purple → red
What is a capsule?
What is the benefit in a capsule for bacteria?
what is the benefit in a capsule for us?
some bacteria have a capsule
extra protection against drugs, phagocytosis etc
highly antigenic → used to develop vaccines
What are pilli?
What do flagellum aid bacteria in?
parts of bacteria that are the sticky outy bits and they are important for adhesion to surfaces/cells
allows bacteria to be motile
What is an endospore and what can it do?
an endospore is like a miniature bacterium that is not a full bacteria cell but under the right conditions can convert into an active bacterial cell
endospores can lay dormant for a long time
What do fungi have instead of cholesterol in their cytoplasm?
What does this help indicate?
ergosterol
indicates cell to be fungi if ergosterol is present
What is a large spread of mould called
mycellium
What is penicillium mould?
What does penicillium look like under a microscope?
a multicellular organism that releases fungal spores
a little brush (penicillium means little brush in Latin)
What is candida albicans and what does it cause?
Why is it considered opportunistic?
yeast = causes oral/genital infections in immunocompromised individuals
it is part of human gut flora and normally doesn’t cause problems unless someone is immunocompromised
What are signs of infections?
redness/ change in skin colour (especially around a wound)
pain or tenderness
heat
swelling
loss of function
What does tachypnoea mean?
fast breathing rate
What is sputum?
similar to mucus
green-yellow indicates infection
red = blood in sputum
What are clinical signs related to specific infections?
increased sputum volume / increased sputum purulence
pus
rashes
cough
pain on urination
nasal congestion
sore throat
What is SIRS criteria used to determine?
criteria to help determine whether patient has inflammation
What are the SIRS criteria?
temperature <36 or >38
Pulse > 90bpm
respiratory rate > 20 breaths per min
White cell count <4 or >11
useful for bacterial infection, less so for viral/fungal
What does SIRS stand for?
systemic inflammatory response syndrome
Is SIRS specific to infection?
no as it just used to determine inflammation (nothing to do with infection although inflammation often due to infection)
What are exogenous sources of infection?
What are endogenous sources of infection?
exogenous → from the host or environment = food, water, soil, coughing and sneezing
endogenous → normal flora from another part of the body = skin pathogens, gut pathogens
Do you wait for outcome of cultures to start treatment?
mostly, no → required to clinically diagnose and give a best guess as to what patient has and then treat based on the empirical evidence
What part of urine stream is used for sample?
mid stream sample → pee pot midway through stream
What can be sampled for bacteriological assessment?
blood cultures
different sites, taken when patient is pyrexial
sputum
urine
pus
bone samples
surgical samples
nail clippings
swabs
wounds
eyes
throat
nose
What is MEWS used for?
Is the Modified Early Warning System and is used to note observations of patient
if the total is 4 or more across parameters then the ward doctor is informed
Parameter | Score | ||||||
3 | 2 | 1 | 0 | 1 | 2 | 3 | |
Respiratory rate | < 8 | 9 – 14 | 15 – 20 | 21 – 29 | > 29 | ||
Heart rate | < 40 | 41 – 50 | 51 – 100 | 101 – 110 | 111 – 129 | > 129 | |
Systolic BP (mmHg) | < 70 | 71 – 80 | 81 – 100 | 101 – 199 | |||
Urine output (ml/kg/hr) | Nil | <0.5 | |||||
Temperature | < 35 | 35.1 – 36 | 36.1 – 38 | 38.1 – 38.5 | > 38.6 | ||
Neurological | Alert | React to voice | React to pain | Unresponsive | |||
What is SEWS used for?
Is the Surgical Early Warning System
Parameter | Score | ||||||
3 | 2 | 1 | 0 | 1 | 2 | 3 | |
RR | > 36 | 31 – 35 | 21 – 30 | 9 – 20 | < 8 | ||
SpO2 (%) | < 85 | 85 – 89 | 90 – 92 | > 93 | |||
Temperature (oC) | > 39 | 38 – 38 .9 | 36 – 37.7 | 35 – 35.9 | 34 – 34.9 | < 33.9 | |
Systolic BP (mmHg) | > 200 | 100 – 199 | 80 – 99 | 70 – 79 | < 69 | ||
HR | > 130 | 110 – 129 | 100 – 109 | 50 – 99 | 40 – 49 | 30 – 39 | < 29 |
Response | Alert | Verbal | Pain | None | |||
-Similar to MEWS but 4 or more = contact doctor for review, 6 or more = urgent review
What are other parameter that can be used to indicate infection?

What is CURB 65?
stands for confusion, urea, respiratory rate, blood pressure and over 65 y/old.
CURB 65 | |
Symptom | Points |
Confusion | 1 |
BUN > 7mmol/L | 1 |
Respiratory rate > 30 | 1 |
SBP < 90mmHg DBP < 60mmHg | 1 |
Age > 65 | 1 |

CURB 65 | |
Symptom | Points |
Confusion | 1 |
BUN > 7mmol/L | 1 |
Respiratory rate > 30 | 1 |
SBP < 90mmHg DBP < 60mmHg | 1 |
Age > 65 | 1 |
What is CRB 65?
a version of CURB 65 that can be done in a pharmacy
0 = low risk of death, normally don’t require hospitalisation
1 or 2 = increased risk of death → hospitalisation considered
3+ = high risk of death → urgent hospital admission
CRB 65 | |
Symptom | Points |
Confusion | 1 |
Respiratory rate > 30 | 1 |
SBP < 90mmHg DBP < 60mmHg | 1 |
Age > 65 | 1 |
What are societal and behavioural barriers to disease?
societal = clean water, waste disposal
behavioural = hand washing, condoms, hospital sterilisation
What are some physiological barriers to disease and what line of defence are they?
skin - physical barrier
mucus membranes e.g. → mouth, nose, eyelids
eyes - lysozymes (provide antimicrobial protection)
1st line of defence
What is the respiratory tract’s physiological barriers to disease?
What is the digestive tract’s physiological barriers to disease?
What is the urogenital tract’s physiological barriers to disease?
mucus and cilia
stomach acid, pancreatic enzymes, bile, peristalsis
urethra, flushing, acidity
What is the second line of defence?
What is part of this defence?
non specific immunity
pyrogens → peptides secreted by leukocytes that act on the hypothalamus to induce fever
interferons → proteins that interfere with viral replication
complement → plasma proteins that destroy cells
phagocytes _. immune cells that engulf foreign particles and act as omnivorous scavengers
What are pyrogens, what do they act on and what do they do?
a peptides that are secreted by leukocytes, act on the hypothalamus and induce fever
non-specific immunity (second line of defence)
What are interferons and what do they do?
proteins that interfere with viral replication
non-specific immunity (second line of defence)
What is complement in non-specific immunity?
plasma proteins that destroy cells
What are the types of phagocytes?
neutrophils - found in blood and tissue, first responders at site of infection
monocytes - roaming phagocytes in the blood that differentiate into macrophages in tissues
fixed phagocytes - organ/ tissue specific e.g. osteoclasts
microglia - CNS resident
dendritic cells - derived from monocytes, often found in tissues in contact with external environment - major role in antigen presentation
What and where are neutrophils?
neutrophils - found in blood and tissue, first responders at site of infection
What and where are monocytes?
monocytes - roaming phagocytes in the blood that differentiate into macrophages in tissues
What and where are dendritic cells?
dendritic cells are derived from monocytes,
often found in tissues in contact with external environment (e.g. skin)
are early warning cells - major role in antigen presentation
How do phagocytes destroy pathogens?
The phagocytic cell is attracted to and recognises microbes as being foreign via surface receptors. It extends filopodia, engulfs the microbe, and early phagosomes begin to form. Once contained in a phagosome, fusion with a digestive enzyme containing lysosome occurs and then breakdown occurs

What is chemotaxis?
chemical attractants (think like signals) released from invading bacteria and tissue leukocytes attract neutrophils, and monocytes from blood stream to go to site of infection
What is diapedesis?
mast cells and basophils release histamine resulting in blood vessel becoming more permeable allowing for more phagocytes to rush to site of infection
How does diapedesis occur in local infection (example)?
Example – pathogenic bacteria have evaded the first line of defence and entered tissue. Tissue resident immune cells respond first, releasing chemicals that cause inflammation. Mast cells and basophils release histamine, which increases the permeability of the endothelium. This allows circulating monocytes to follow a chemotactic gradient towards the site of infection (chemotaxis), and reach the tissue by squeezing through small gaps in fine blood vessels (diapedesis). The monocytes can rapidly differentiate into phagocytic tissue macrophages.
What is dendritic cell role in response to infection?
constantly sample milieu (their local environment) for presence of any foreign antigens
use pattern recognition receptors (PPRs) and toll-like receptors (TLRs) to do this
engulf and digest foreign pathogens that can then be captured by MHC-II proteins that are within the cell
The MHC-II/pathogen complex travels to the cell surface of the dendritic cell
the dendritic cell travels to the lymph node where it then interacts with B and T cells

Why did Von Behring win a Nobel prize 1901?

discovered exposure to toxin = immunity
serum from B to C = transferred immunity
discovered that immunity is only specific to that specific toxin and not to an alternative (animal D)
mans discovered antibodies and antigens
What is specific immunity?
What are the stages of immune response when immune system comes across pathogen?
third line of defence
challenge → recognition → activation → elimination
What is an epitope of an antigen?
How many antibodies can recognise an epitope?
it is the antigenic determining site that the antibodies can act on
1
Are antigens made up of high or low molecular substances
usually high MW substances e.g. - proteins
What are haptens?
Why do haptens illicit immune response when bound to a carrier molecule?
Are low MW compounds that can bind to antibodies but don’t illicit an immune response unless they are bound to a carrier molecule
Because the molecular weight increases
What is urushiol?
How does it illicit a T-cell response?
it is a hapten from poison ivy
When urushiols oxidises → product attaches to skin proteins = T-cell reaction results in severe blistering
What antibiotic can act as a hapten to susceptible patients?
penicillin → leads to anaphylaxis reaction
What is humoral immunity?
Does it act directly or indirectly?
it is antibody mediated (immunoglobulins and B cells)
Acts indirectly
Does cell mediated immunity act directly or indirectly?
acts directly
What is the structure of an antibody?
variable region (binds specific antigens fragments) (fab)
Constant region (our cells recognise quickly so don’t get mistaken as pathogens)
4 polypeptide chains cross-linked by disulphide bridges

Describe the differences between MADGE immunoglobulins?

How do antibodies eliminate antigens?
opsonisation → promotion of phagocytes
Neutralisation
Complement activation
What does opsonisation result in (in steps)?
pathogen gets coated by antibodies causing them to be targeted for destruction by macrophages and other cytotoxic cells
Variable region of antibody binds to pathogen, constant region free
Constant region Binds to receptors on macrophages and indicate that the pathogen is to be phagocytosed
What does neutralisation result in?
When serum from a survivor gets transferred to someone else, it allows for the binding and neutralisation of the venom molecules
How do complement proteins get activated to destroy pathogens?
Why does high conc of Ca2+ destroy the cell?
complement cascade where predecessor cleaves its successor in a chain
The cleaved pieces assemble together to form a pore, the pore allows high conc of Ca 2+ to accumulate in the cells and destroy them
Causes an increase in osmotic pressure resulting in cell bursting
What are the 3 lymphocytes involved in cell mediated immunity?
B cells
Stimulated to produce antibodies
Can differentiate into plasma cells
Mature in the bone marrow
T cells
2 subtypes → cytotoxic and helper T-cells
Mature in the thymus
Nature killer cells
NK cells
Kill virus infected/ cancerous cells

Where do B cells mature?
in the bone marrow (B cell = bone)
Where do T cells mature?
In the thymus (T = thymus)
What do plasma B-cells produce?
What do memory B-cells lead to?
How are B-cells activated?
produce antibodies
Secondary immune response
Are activated when antigens bind to immunoglobulin receptors on the B cell surface